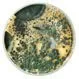
Mold Exposure
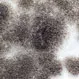
What Can Black Mold Do to You Mentally?

Trending Allergies Topics
Allergy/Allergies
Allergens (allergy triggers) include pollens, dust mites, molds, dander, and certain foods. Hay fever, asthma, allergic eyes, allergic eczema, hives, and allergic shock are common allergy disorders.
Bad Bugs and Their Bites
Watch this slideshow of bad bugs and insect pictures. Learn how to identify bug bites such as the mosquito, bees, spider, bed bugs, wasp and see what their bites & stings look like and how to find relief.
Allergies Quiz
What are the causes of allergies? This online quiz challenges your knowledge of common food and household allergens, environmental triggers, allergic diseases and conditions, and allergy symptoms and treatments.
Sinus Infection
Learn about sinus infection (sinusitis) signs and symptoms such as headache, fever, and facial tenderness, pressure, or pain. Treatment of sinus infections are generally with antibiotics.
Contact Dermatitis
View a picture of allergic contact dermatitis (tattoo) and learn more about other this and other allergic skin disorders.
Allergy Triggers
Learn about common allergy triggers through this photo pictures slideshow. Allergies are an overreaction of the immune system where the body's defenses react to substances such as pollen, food, hay fever and more.
Related Disease Conditions
 10 Best Natural Home Remedies for Sinus Infections (Sinusitis)
10 Best Natural Home Remedies for Sinus Infections (Sinusitis)What is a sinus infection (sinusitis)? Learn whether you need antibiotics and what other treatments and home remedies can help to relieve your symptoms.
 11 Facts About Sneezes and Sneezing
11 Facts About Sneezes and SneezingSneezing is a common experience we all share. It is your body's method of removing anything that may be irritating the nose. Sneezing, in scientific terms, is also called sternutation.
 Allergic Cascade
Allergic CascadeThe allergic cascade refers to allergic reactions that happen in the body in response to allergens. A variety of immune cells and chemical messengers participate in the allergic cascade. Symptoms of the allergic cascade range from mild swelling and itching to full-blown anaphylactic shock. Allergen avoidance and medications are used to prevent or treat allergies.
 Allergy
AllergyAn allergy refers to a misguided reaction by our immune system in response to bodily contact with certain foreign substances. When these allergens come in contact with the body, it causes the immune system to develop an allergic reaction in people who are allergic to it. It is estimated that 50 million North Americans are affected by allergic conditions. The parts of the body that are prone to react to allergies include the eyes, nose, lungs, skin, and stomach. Common allergic disorders include hay fever, asthma, allergic eyes, allergic eczema, hives, and allergic shock.
 Allergy Treatment Begins at Home
Allergy Treatment Begins at HomeAvoiding allergy triggers at home is one of the best ways to prevent allergy symptoms. Controlling temperature, humidity, and ventilation are a few ways to allergy-proof the home. Cleaning, vacuuming, and using HEPA air filters also helps control allergies.
 Anaphylaxis
AnaphylaxisAnaphylaxis is a serious allergic reaction that affects a number of different areas of the body at one time and can be fatal. Causes of anaphylaxis can be a food allergy, latex allergy, allergy to insect stings/bites, asthma, or other materials or conditions. Symptoms include flushing, itching, hives, anxiety, and rapid or irregular pulse. Severe symptoms may be throat and tongue swelling, swallowing, and difficulty breathing. Some disorders appear similar to anaphylaxis such as fainting, panic attacks, blood clots in the lungs, heart attacks, and septic shock. If you think that you may be having an anaphylactic reaction, seek emergency care or call 911 immediately.
 Are Food Allergies Passed Down Genetically?
Are Food Allergies Passed Down Genetically?A food allergy is a condition that causes your immune system to fight against a particular part of food — which is called an allergen. Food allergies can be hereditary — that is, parents can pass the likelihood of developing a food allergy to their children through genes that code for inherited traits.
 Bee and Wasp Sting
Bee and Wasp StingBees, wasps, and fire ants are related insects that belong to the Hymenoptera order. There are thousands of species of wasps found throughout the world. Common wasps are yellow jackets and hornets. Types of bees include honey bees, the Africanized honey bee (killer bee), and the bumble bee. There are four types of reactions to a bee or wasp sting; local reaction, systemic allergic reaction, toxic reaction, and delayed reaction. Individuals who have a systemic or toxic reaction generally require immediate medical treatment to prevent anaphylactic reaction, and possibly death.
 Can Eating Eggs Make You Nauseous?
Can Eating Eggs Make You Nauseous?Why do eggs make you nauseous? Learn what causes nausea after eating eggs and what to do about it.
 Can Fall Allergies Cause Sinus Headaches?
Can Fall Allergies Cause Sinus Headaches?Fall allergies can cause symptoms such as sneezing, congestion, and sinus headache. Learn more about causes, treatment, and prevention of fall allergies.
 Can Hot Weather Cause Sinus Problems?
Can Hot Weather Cause Sinus Problems?Sinusitis is a condition where you experience irritation and swelling of your sinuses. Allergies and sinus problems are common during the warmer seasons.
 Can You Eat Avocado if You Have a Nut Allergy?
Can You Eat Avocado if You Have a Nut Allergy?Since avocado is classified as a fruit and not a tree nut, you should be able to eat avocados even if you have a nut allergy. However, some studies have shown that avocados have similar proteins as chestnuts. So if you’re allergic to chestnuts, you may have to avoid avocados.
 Can You Suddenly Become Allergic to Cats?
Can You Suddenly Become Allergic to Cats?Yes, it is possible to suddenly become allergic to cats, since various allergies can develop at any point in your life, such as a pet allergy.
 Can You Suddenly Become Lactose Intolerant?
Can You Suddenly Become Lactose Intolerant?People may become lactose intolerant at any point of time in their lives.
 Chronic Rhinitis
Chronic RhinitisChronic rhinitis (non-allergic rhinitis) causes runny nose, sneezing, nasal itching, and congestion. Post-nasal drip is the drainage of mucus from the sinuses into the throat. Treatment includes over-the-counter (OTC) medications.
 Cosmetic Allergies
Cosmetic AllergiesFragrances and preservatives in cosmetics may cause allergic reactions in some people. Symptoms include redness, itching, and swelling after the product comes in contact with the person's skin. Treatment typically involves the use of over-the-counter cortisone creams.
 Drug Allergy
Drug AllergyDrug or medication allergies are caused when the immune system mistakenly creates an immune response to a medication. Symptoms of a drug allergic reaction include hives, rash, itchy skin or eyes, dizziness, nausea, diarrhea, fainting, and anxiety. The most common drugs that people are allergic to include penicillins and penicillin type drugs, sulfa drugs, insulin, and iodine. Treatment may involve antihistamines or corticosteroids. An EpiPen may be used for life-threatening anaphylactic symptoms.
 Eye Allergy
Eye AllergyEye allergy (or allergic eye disease) are typically associated with hay fever and atopic dermatitis. Medications and cosmetics may cause eye allergies. Allergic eye conditions include allergic conjunctivitis, conjunctivitis with atopic dermatitis, vernal keratoconjunctivitis, and giant papillary conjunctivitis. Dry eye, tear-duct obstruction, and conjunctivitis due to infection are frequently confused with eye allergies. Eye allergies may be treated with topical antihistamines, decongestants, topical mast-cell stabilizers, topical anti-inflammatory drugs, systemic medications, and allergy shots.
 Food Allergy
Food AllergyThe most common food allergies are to eggs, nuts, milk, peanuts, fish, shellfish, strawberries and tomatoes. Symptoms and signs of a food allergy reaction include nausea, vomiting, diarrhea, abdominal pain, itching, hives, eczema, asthma, lightheadedness, and anaphylaxis. Allergy skin tests, RAST, and ELISA tests may be used to diagnose a food allergy. Though dietary avoidance may be sufficient treatment for mild allergies, the use of an Epipen may be necessary for severe food allergies.
 Hay Fever
Hay FeverHay fever (allergic rhinitis) is an irritation of the nose caused by pollen and is associated with the following allergic symptoms: nasal congestion, runny nose, sneezing, eye and nose itching, and tearing eyes. Avoidance of known allergens is the recommended treatment, but if this is not possible, antihistamines, decongestants, and nasal sprays may help alleviate symptoms.
 How Can I Help My Child With a Peanut Allergy?
How Can I Help My Child With a Peanut Allergy?Since there is no cure for peanut allergies, prevention and keeping an epinephrine injector (EpiPen) on hand is key to helping your child’s allergy.
 How Can You Tell if You Have a Sinus Infection?
How Can You Tell if You Have a Sinus Infection?Sinus infection is a common issue that affects many people. Learn the signs of sinus infection, what causes sinus infection, how doctors diagnose sinus infection, and what you can do to treat sinus infection.
 How Do I Know If I Have Histamine Intolerance?
How Do I Know If I Have Histamine Intolerance?The symptoms of histamine intolerance often resemble seasonal or food allergies, which means proper diagnosis requires an evaluation from a doctor.
 How Do You Calm Down an Allergy Attack?
How Do You Calm Down an Allergy Attack?Here are thirteen tips to calm an allergy attack and put an end to constant sneezing, itching, and congestion.
 How Do You Get Tested for Food Allergies?
How Do You Get Tested for Food Allergies?If you develop symptoms of a food allergy, your doctor will have you undergo a skin test or blood test to determine which foods you are allergic to.
 How Do You Know If You Are Allergic to Mosquito Bites?
How Do You Know If You Are Allergic to Mosquito Bites?Mosquito bite allergies can cause issues if untreated. Learn the signs of a mosquito bite allergy, what causes it, and what you can do to treat it.
 How Long Does an Allergic Reaction Last?
How Long Does an Allergic Reaction Last?Allergic reactions may last for varying lengths of time. They may take a few hours to a few days to disappear. If the exposure to the allergen continues, such as during a spring pollen season, allergic reactions may last for longer periods such as a few weeks to months.
 How Much Does an EpiPen Cost?
How Much Does an EpiPen Cost?EpiPen typically comes in a pack of two and costs roughly between $650-$700. Generic versions may cost between $150-$400 if you pay in cash.
 Indoor Allergens
Indoor AllergensIndoor allergens are substances that can cause an allergic reaction in some people. Common sources of indoor allergens include dust mites, cockroaches, molds, pets, and plants. Avoiding indoor allergens is one way to reduce allergy and asthma symptoms.
 Insect Sting Allergies
Insect Sting AllergiesThe majority of stinging insects in the United States are from bees, yellow jackets, hornets, wasps, and fire ants. The severity of reactions to stings varies greatly. Avoidance and prompt treatment are essential. In selected cases, allergy injection therapy is highly effective.
 Is Food Intolerance the Same as Food Allergy?
Is Food Intolerance the Same as Food Allergy?Food intolerance is a condition in which an individual has difficulty in digesting certain foods. Consumption of these foods manifests as physical symptoms such as bloating, loose motion, gases, and bellyache. Food intolerance is quite common. Most people are aware of the foods that disagree with them.
 Is It Possible to Be Allergic to Cinnamon?
Is It Possible to Be Allergic to Cinnamon?Cinnamon is a popular spice in many dishes. Cinnamon gives dishes a distinct flavor. Only a small percent of people experience allergic reactions after ingesting or coming into contact with cinnamon.
 Is the Black Mold in My Shower Toxic?
Is the Black Mold in My Shower Toxic?Mold in your shower can cause annoying symptoms and health problems in people who are sensitive to it. Learn the signs of mold exposure, what causes it, how doctors diagnose it, and what you can do to treat it.
 Latex Allergy
Latex AllergyLatex allergy is a condition where the body reacts to latex, a natural product derived from the rubber tree. The reaction can either be delayed and cause a skin rash or immediate, which can lead to anaphylaxis. Avoiding latex is the most effective way to prevent an allergic reaction.
Mold Exposure
Mold ExposureMold exposure may cause symptoms in people who are sensitive to mold. Symptoms of mold allergy include sneezing, runny nose, wheezing, coughing, redness of the eyes, and rash. Prevent mold growth by keeping indoor humidity low, between 30%-50%, using bathroom fans when showering, repairing plumbing leaks quickly, and using an air conditioner during humid seasons.
 Mucus
MucusMucus is a standard substance produced by lining tissues in the body. Excess mucus or yellow, green, brown, or bloody mucus may indicate a problem. Mucus production may increase when allergies, a cold, flu, cough, or sore throat occur. Antihistamines and cold and flu medications may help alleviate excess mucus. A neti pot may be used to decrease nasal congestion and clear mucus.
 Nosebleed
NosebleedNosebleeds are common in dry climates during winter months, and in hot dry climates with low humidity. People taking blood clotting medications, aspirin, or anti-inflammatory medications may be more prone to nosebleeds. Other factors that contribute to nosebleed are trauma (including nose picking, especially in children), rhinitis (both allergic and nonallergic), and high blood pressure. First-aid treatments for a nosebleed generally do not need medical care. Frequent or chronic nosebleeds may require medical treatment such as over-the-counter (OTC) medication, and prevention of nose picking.
 Peanut Allergy
Peanut AllergyPeanut allergies cause signs and symptoms that include hives, itching, redness, and a rash. Severe reactions may cause decreased blood pressure, lightheadedness, difficulty breathing, nausea, and behavioral changes. Someone with a peanut allergy should have an EpiPen with them at all times.
 Sinus Headache
Sinus HeadacheSinus headache is caused by a sinus infection or inflammation of the sinus cavities. Symptoms of a sinus headache include pain, runny or stuffy nose, and chronic cough. There are many causes of sinus headaches including sinusitis or sinus infection, allergies, smoke, infections, or colds. Treatment for sinus headaches depends on the cause. Some home remedies may relieve sinus headache pain symptoms.
 Sinus Infection vs. Allergies
Sinus Infection vs. AllergiesBoth sinus infections and allergies (allergic rhinitis) cause symptoms such as runny or stuffy nose and fatigue. Sinus infection (known as sinusitis) is inflammation of the sinuses, caused by infection from bacteria, viruses, and/or fungi (molds). Allergic rhinitis occurs when certain allergies cause nasal symptoms. When a person with allergies breathes in an allergen, such as pollen, dust, or animal dander, symptoms such as runny or stuffy nose, itching, sneezing, and fatigue occur.
 Sinusitis
SinusitisSinus infection (sinusitis) is caused by allergies, infection, and chemicals or other irritants of sinuses. Signs and symptoms include headache, fever, and facial tenderness, pressure, or pain. Treatments of sinus infections are generally with antibiotics and at times, home remedies.
 What Are Symptoms of Mast Cell Activation Syndrome?
What Are Symptoms of Mast Cell Activation Syndrome?Mast cell activation syndrome (MCAS) can cause allergy symptoms. Learn about causes, diagnosis, and treatment.
 What Are the 12 Food Allergens?
What Are the 12 Food Allergens?According to studies, the twelve most common food allergens include milk, peanuts, eggs, shellfish, soy, tree nuts, wheat, fish, corn, sesame seeds, mustard, and celery. Check out the center below for more medical references on food allergens, including multimedia (slideshows, images, and quizzes), related disease conditions, treatment and diagnosis, medications, and prevention or wellness.
 What Are the 20 Most Allergic Foods?
What Are the 20 Most Allergic Foods?Common food allergies include milk, eggs, peanuts, tree nuts, sesame, soy, fish, shellfish, and wheat. Here are 20 of the top food allergies.
 What Are the 4 Types of Allergic Reactions?
What Are the 4 Types of Allergic Reactions?Allergists recognize four types of allergic reactions: Type I or anaphylactic reactions, type II or cytotoxic reactions, type III or immunocomplex reactions and type IV or cell-mediated reactions.
 What Are the Best Treatments for Allergic Conjunctivitis?
What Are the Best Treatments for Allergic Conjunctivitis?Learn what medical treatments can ease allergic conjunctivitis symptoms and help speed up your eye allergy recovery.
 What Are the Most Common Food Intolerances?
What Are the Most Common Food Intolerances?Food intolerance is a condition in which a person is unable, or finds it difficult to digest certain foods, and experiences gastrointestinal disturbances when they eat such foods. Food intolerance occurs when the digestive system cannot break down certain ingredients in food.
 What Are the Symptoms of a Milk Allergy in Adults?
What Are the Symptoms of a Milk Allergy in Adults?Milk allergy reactions may cause immediate or delayed symptoms. Learn to spot the signs and what foods to avoid if you have a dairy allergy.
 What Are the Symptoms of Ragweed Allergy?
What Are the Symptoms of Ragweed Allergy?The common symptoms of ragweed allergy are sneezing, runny nose, itchy, watery red eyes, headache, nasal congestion, eye swelling, rashes and coughing.
 What Can Black Mold Do to You Mentally?
What Can Black Mold Do to You Mentally?Black mold is the common name for Stachybotrys chartarum. The mental effects of black mold include irritability, fatigue, concentration problems, sleep problems, lightheadedness, and headache.
 What Causes Allergy Flare-ups?
What Causes Allergy Flare-ups?During certain seasons, allergies can make you miserable. Learn what causes allergy flare-ups during spring and summer.
 What Causes Sudden Allergies in Adults?
What Causes Sudden Allergies in Adults?Can you develop allergies as an adult? Learn about what causes sudden adult-onset allergies and how you can recognize the symptoms.
What Does Black Mold Do To You?
What Does Black Mold Do To You?Black mold is one of many molds that can cause allergic symptoms like sneezing, coughing, wheezing, and skin rashes. Learn the signs of mold exposure, what causes it, how doctors diagnose it, and what you can do to treat it.
 What Foods Cause Oral Allergy Syndrome?
What Foods Cause Oral Allergy Syndrome?Oral allergy syndrome, also called pollen food allergy syndrome or PFAS, is a type of food allergy caused by certain allergens found in both pollen and raw vegetables and fruits and some nuts. Foods that cause oral allergy syndrome include those in the birch, grass and ragweed families.
 What Is the Best Treatment for Urticaria?
What Is the Best Treatment for Urticaria?Learn what medical treatments can help ease your urticaria symptoms and speed up your recovery.
 What Is the Fastest Way to Fix Seasonal Allergies?
What Is the Fastest Way to Fix Seasonal Allergies?Seasonal allergies are common and tend to ramp up during the spring and summer. Learn about how to get rid of seasonal allergies fast with these 13 home remedies.
 What Is the Most Common Tree Nut Allergy?
What Is the Most Common Tree Nut Allergy?The most common nut allergies are cashew, walnut, hazelnut and pistachio. In the U.S. the most common nut allergy is cashew, followed by walnut. In the U.K. the most common nut allergy is hazelnut.
 What Nuts Are the Worst for Allergies?
What Nuts Are the Worst for Allergies?A nut allergy develops when the body's immune system becomes oversensitive to a particular protein in a nut. Nuts that are the worst for allergies include peanuts, walnuts, pecans, almonds, Brazil nuts and pine nuts.
 What Should I Do If I Get Stung by a Scorpion?
What Should I Do If I Get Stung by a Scorpion?Most healthy adults don’t need treatment for a scorpion sting except for pain relief. However, here are some home remedies for treating a sting and when you should seek medical help.
 Why Won’t My Allergy Symptoms Go Away?
Why Won’t My Allergy Symptoms Go Away?Allergies happen when your body's immune system reacts to certain substances as though they are harmful. Allergy symptoms may not go away unless you avoid your triggers, stick to your medications, find the right combination of medications, and consider surgery.
Multimedia: Slideshows, Images & Quizzes
 10 Signs Your Allergies Are Out of Control
10 Signs Your Allergies Are Out of ControlLearn 10 signs your allergies are out of control. See these surprising allergy symptoms and find out how to get relief for sneezing, congestion, watery eyes, and more.
 10 Worst Cities for Spring Allergies
10 Worst Cities for Spring AllergiesSee pictures of the top 10 "spring allergy capitals", according to the Asthma and Allergy Foundation of America (AAFA). From coast to coast, see if your city made the top 10.
 12 Natural Ways to Defeat Allergies
12 Natural Ways to Defeat AllergiesAllergies making you miserable? WebMD shows you a dozen natural allergy treatments, from fresh fruit and vitamin D to acupuncture and air filters.
 Allergies Quiz: Symptoms & Home Remedies
Allergies Quiz: Symptoms & Home RemediesWhat are the causes of allergies? This online quiz challenges your knowledge of common food and household allergens, environmental triggers, allergic diseases and conditions, and allergy symptoms and treatments.
 Allergies: 10 Ways to Reduce Mold Allergies
Allergies: 10 Ways to Reduce Mold AllergiesWebMD shows you 10 ways to fight the fungus and reduce mold allergy symptoms from dust masks to bottles of bleach.
 Allergies: Common Plants and Trees That Trigger Allergies
Allergies: Common Plants and Trees That Trigger AllergiesFind out more about which plants and trees might be producing pollen that is causing your itchy eyes and a runny nose.
 Allergies: Myths and Facts About Seasonal Allergies
Allergies: Myths and Facts About Seasonal AllergiesSeasonal allergy symptoms are hard. Do deserts prevent allergies? What can allergies do to your body? What is an allergen? Adult allergies can pop up unexpectedly, and sometimes childhood allergies disappear completely. Learn why, along with answers to various allergy questions, as we separate allergy myth from fact.
 Allergies: Signs of a Severe Allergic Reaction
Allergies: Signs of a Severe Allergic ReactionFind out from WebMD's slideshow how to tell if you or someone near you is having a severe allergic reaction.
 Bad Bugs: Identify Insects and Bug Bites
Bad Bugs: Identify Insects and Bug BitesWhat do bug bites look like? How do you treat bug bites? Why do bug bites burn? See spider bite pictures and learn how to identify bug bites from mosquitoes, bees, bed bugs, wasps, and more. See what their bites & stings look like and how to treat bug bites. For more details, enter a search for the specific insects or bugs as this slideshow is a brief introduction to the topic.
 Best and Worst Foods for Lung Health
Best and Worst Foods for Lung HealthJust like the rest of your body, your lungs need good nutrition. Find out what types of foods are lung-friendly, and which aren’t.
 Common Allergies: Symptoms and Signs
Common Allergies: Symptoms and SignsWhat are allergies? Pollen, food, perfumes, and many more things can provoke allergy symptoms. Allergies are an overreaction of the immune system where the body's defenses react to certain allergens. Learn about common allergy triggers and how you can avoid an allergy attack.
 Dangerous Allergies: Anaphylaxis and Life-Threatening Allergy Triggers
Dangerous Allergies: Anaphylaxis and Life-Threatening Allergy TriggersCommon allergy triggers may provoke anaphylaxis. Hives, tongue swelling, face swelling, rashes, low blood pressure, rapid and weak pulse and difficulty breathing are just a few symptoms that occur with anaphylaxis.
 Home Allergy Quiz: Is Your Home Allergy-Proof?
Home Allergy Quiz: Is Your Home Allergy-Proof?Take this home allergy quiz and test your knowledge on allergens, dust mites, pollens and more to see how allergy-proof your home is.
 Home Health: Meet the Bugs That Live In Your House
Home Health: Meet the Bugs That Live In Your HouseGet to know your bug bunkmates: WebMD introduces you to the critters that share your home with you. From ants, roaches, and beetles to spiders, silverfish and more.
 Human Body Quiz: Human Body Systems & Organs
Human Body Quiz: Human Body Systems & OrgansThe Human Body Quiz will help you learn about your little-known body parts! Take this quiz to learn more about your body and what goes on inside.
 Itchy Eyes? Top 13 Ways to Tame Eye Allergies
Itchy Eyes? Top 13 Ways to Tame Eye AllergiesDo you need eye drops? Eye allergies, or allergic conjunctivitis, cause itchy eyes and other allergic symptoms. Avoiding allergens and using medicated eye drops can help. Learn about eye allergy triggers like mold and pollen, and eye allergy relief like shots and eye drops.
 Nasal Allergy Attack: Causes, Triggers, Treatments
Nasal Allergy Attack: Causes, Triggers, TreatmentsNasal allergies are a common problem that affects millions of people. An allergist can recommend the best allergy nasal sprays and other medications to treat allergy symptoms. OTC allergy nasal sprays, prescription nasal sprays for allergies, and other treatments are available.
 Nasal Irrigation: Natural Relief for Cold & Allergy Symptoms
Nasal Irrigation: Natural Relief for Cold & Allergy SymptomsClogged sinuses and congestion bothering you? Nasal irrigation can relieve sinus symptoms associated with colds and allergies. Learn how to do nasal irrigation with this visual guide from WebMD.
 Picture of Allergic Contact Dermatitis (Arm)
Picture of Allergic Contact Dermatitis (Arm)Allergic Contact Dermatitis on Arm. This example of allergic contact dermatitis is a reaction to a henna tattoo on the arm, after ten days. Contact dermatitis is a type of eczema caused either by a toxic reaction to some substance or by an allergic reaction. The rash will generally clear up on its own if you can avoid contact with the what triggered it in the first place.
 Picture of Allergic Contact Dermatitis (Tattoo)
Picture of Allergic Contact Dermatitis (Tattoo)Allergic contact dermatitis. This is reaction by your skin after coming into contact to some substance that you are allergic to. It is usually a rash that can be red and itchy and sometimes blister.
 Picture of Nickel Contact Dermatitis
Picture of Nickel Contact DermatitisNickel contact dermatitis. This itchy rash is a common allergic reaction to your skin coming into contact with nickel from perhaps a metal snap on blue jeans, a metal belt buckle, or nickel jewelry like earrings or watches. The lesions usually appear around the belly button but can also develop on the elbows and knees. Though general mild, they symptoms can be debilitating with prolonged exposure. Once you’ve had nickel contact dermatitis, you are susceptible to it occurring again so you should strictly try to avoid contact with nickel.
 Picture of Nickel Contact Dermatitis from Necklace
Picture of Nickel Contact Dermatitis from NecklaceNickel contact dermatitis. This itchy rash is a common allergic reaction to your skin coming into contact with nickel from perhaps nickel jewelry like watches or earrings, a metal snap on blue jeans, or a metal belt buckle. The lesions usually appear around the belly button but can also develop on the elbows and knees. Though general mild, they symptoms can be debilitating with prolonged exposure. Once you’ve had nickel contact dermatitis, you are susceptible to it occurring again so you should strictly try to avoid contact with nickel.
 Picture of Phototoxic Dermatitides
Picture of Phototoxic DermatitidesPhototoxic Dermatitides appears as photosensitivity reaction after a person takes certain medications or applies skin care products that contain a photosensitizing agent. It appears after the person is exposed to the sun or UV light. The best treatment is preventativie methods such as avoiding the sun, covering up in daylight and stopping the offending medication or product.
 Picture of Sinuses
Picture of SinusesThe sinuses are an air-filled cavity in a dense portion of a skull bone. See a picture of the Sinuses and learn more about the health topic.
 Pictures of Allergy Relief Tips at Home: AC Filters, Electronic Air Cleaners, and More
Pictures of Allergy Relief Tips at Home: AC Filters, Electronic Air Cleaners, and MoreLearn how a combination of medication, preventing allergens, and allergy relief products can reduce allergy symptoms and help you feel better.
 Preparing for Severe Allergies at School
Preparing for Severe Allergies at SchoolHelp your child manage and prepare for severe allergies at school. Protect your child from food allergies, insect stings, and more. Learn how to set up an action plan for allergies at school.
 Sinus Infection: Sinusitis Dos and Don'ts
Sinus Infection: Sinusitis Dos and Don'tsIs it OK to fly when you've got sinusitis? How about going to work? WebMD helps you decide what's right and wrong when you're all stuffed up.
 STD Quiz: Symptoms, Testing & List
STD Quiz: Symptoms, Testing & ListThere are more sexually transmitted diseases than just the ones you've heard of. Find out what you've been missing with the STD Quiz.
 The Most Common Food Allergies for Kids and Adults
The Most Common Food Allergies for Kids and AdultsWhat common food allergens cause the most problems for adults and children? See this list of common food allergies and learn to avoid allergens with these tips.
 Top Items for Your Allergy Relief Kit
Top Items for Your Allergy Relief KitBe prepared for your next allergy attack no matter where you are. WebMD shows you what you need in your allergy kit to help relieve symptoms.
 When Animal (Allergies) Attack: Pet Allergy Symptoms, Treatment
When Animal (Allergies) Attack: Pet Allergy Symptoms, TreatmentHow do you control and relieve pet allergies? How do you prevent pet allergies? Learn dog and cat allergy symptoms, the cause of allergies to cats and dogs, how to clean up for pet allergies, and the truth about hypoallergenic dogs and cats. Discover how to treat symptoms of pet allergies.
Treatment & Diagnosis
Medications & Supplements
- Adrenaclick (epinephrine)
- Antihistamine Shots (Injections)
- Antihistamines (Oral)
- Arcalyst (rilonacept)
- avelumab
- azelastine (Astelin, Astepro)
- beclomethasone dipropionate inhaler (Beconase AQ, QNASL)
- beclomethasone dipropionate nasal inhaler-spray
- Beconase AQ (beclomethasone) Side Effects, Warnings, and Drug Interactions
- budesonide nasal inhaler (Rhinocort Allergy, Rhinocort Aqua)
- cetirizine (Zyrtec, Zyrtec Allergy, Zyrtec Hives)
- chlorpheniramine
- chlorpheniramine/pseudoephedrine
- cortisone
- cyproheptadine
- cyproheptadine (Periactin)
- decongestant spray - nasal
- desloratadine (Clarinex, Clarinex Reditabs)
- diphenhydramine
- Dymista (azelastine hydrochloride and fluticasone propionate)
- epinephrine injection (Auvi-Q)
- EpiPen (epinephrine auto-injector)
- fexofenadine (Allegra, Mucinex Allergy)
- fexofenadine and pseudoephedrine (Allegra-D)
- Firdapse (amifampridine)
- flunisolide nasal spray, Aerospan (Nasalide, Aerobid, Aerobid HFA are discontinued)
- fluticasone
- fluticasone furoate nasal spray (Veramyst)
- house dust mite immunotherapy
- hydroxyzine
- hypotonic saline intranasal
- ipratropium
- levocetirizine
- loratadine
- loratadine and pseudoephedrine (Alavert Allergy & Sinus, Claritin-D, Claritin-D 24 hour)
- loratadine, Claritin, Claritin RediTabs, Alavert, Claritin Hives Relief, Children's Claritin
- modified ragweed tyrosine adsorbate
- mometasone furoate
- naphazoline
- Nasal Decongestants
- oxymetazoline intranasal
- Polmon (dexchlorpheniramine maleate)
- promethazine
- pseudoephedrine
- quercetin
- Quzyttir (cetirizine)
- Side Effects of Allegra (fexofenadine)
- Side Effects of Allegra D (fexofenadine and pseudoephedrine)
- Side Effects of Auvi-Q (auto-injectable epinephrine)
- Side Effects of Clarinex (desloratadine)
- Side Effects of Claritin (loratadine)
- Side Effects of Claritin D (loratadine/pseudoephedrine)
- Side Effects of Cortef (hydrocortisone)
- Side Effects of EpiPen (auto-injectable epinephrine)
- Side Effects of Flonase (fluticasone)
- Side Effects of Nasacort AQ (triamcinolone acetonide)
- Side Effects of Nasalcrom (cromolyn sodium)
- Side Effects of Nasonex (mometasone furoate)
- Side Effects of Periactin (cyproheptadine)
- Side Effects of Phenergan (promethazine)
- Side Effects of Rayos (prednisone)
- Side Effects of Rhinocort Aqua (budesonide)
- Side Effects of Veramyst (fluticasone)
- Side Effects of Vistaril (hydroxyzine)
- Side Effects of Xyzal (levocetirizine dihydrochloride)
- Side Effects of Zyrtec (cetirizine)
- sodium chloride intranasal
- Symjepi (epinephrine)
- terfenadine, Seldane
- triamcinolone
- triamcinolone acetonide nasal inhaler (Nasacort)
- Zetonna (ciclesonide)
Prevention & Wellness
- Is There a Benadryl for Infants?
- Salicylate Sensitivity Causes, Symptoms, and Foods to Avoid
- Super Bowl Party Recipes (Healthy and Easy)
- What Does Sun Allergy Rash Look Like?
- What Foods Are Bad for Allergies?
- What Foods Are Tested in Allergy Testing?
- What Helps Relieve Allergies Fast?
- Why Do My Allergies Get Worse at Night?





